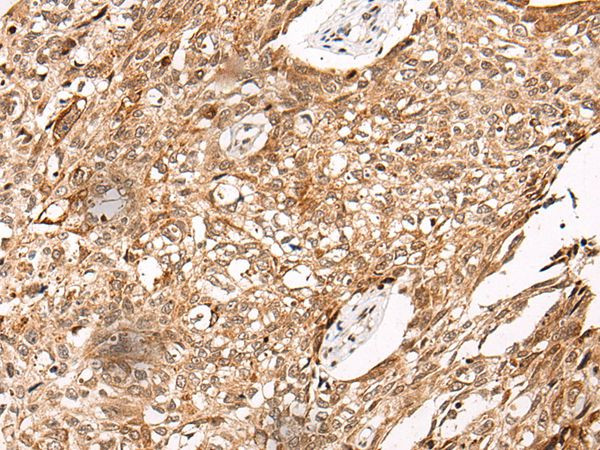
NO66 Antibody in Immunohistochemistry (Paraffin) (IHC (P))

Search
Invitrogen
NO66 Polyclonal Antibody
{{$productOrderCtrl.translations['antibody.pdp.commerceCard.promotion.promotions']}}
{{$productOrderCtrl.translations['antibody.pdp.commerceCard.promotion.viewpromo']}}
{{$productOrderCtrl.translations['antibody.pdp.commerceCard.promotion.promocode']}}: {{promo.promoCode}} {{promo.promoTitle}} {{promo.promoDescription}}. {{$productOrderCtrl.translations['antibody.pdp.commerceCard.promotion.learnmore']}}

Please note: We are reviewing Western blot images included in the antibody testing data in our catalog, including those provided by third parties. Unless expressly labeled or annotated as “raw-unedited”, Western blot images included in the antibody testing data in our catalog may have been edited, optimized or otherwise adjusted for presentation.
产品信息
PA5-67597
种属反应
宿主/亚型
分类
类型
抗原
偶联物
形式
浓度
规格
纯化类型
保存液
内含物
保存条件
运输条件
RRID
产品详细信息
Predicted to react with Mouse and Rat samples.
靶标信息
Oxygenase that can act as both a histone lysine demethylase and a ribosomal histidine hydroxylase. Specifically demethylates 'Lys-4' (H3K4me) and 'Lys-36' (H3K36me) of histone H3, thereby playing a central role in histone code. Preferentially demethylates trimethylated H3 'Lys-4' (H3K4me3) and monomethylated H3 'Lys-4' (H3K4me1) residues, while it has weaker activity for dimethylated H3 'Lys-36' (H3K36me2). Also catalyzes the hydroxylation of 60S ribosomal protein L8 on 'His-216'. Acts as a regulator of osteoblast differentiation via its interaction with SP7/OSX by demethylating H3K4me and H3K36me, thereby inhibiting SP7/OSX-mediated promoter activation. May also play a role in ribosome biogenesis and in the replication or remodeling of certain heterochromatic region. Participates in MYC-induced transcriptional activation. [UniProt]
仅用于科研。不用于诊断过程。未经明确授权不得转售。
篇参考文献 (0)
生物信息学
蛋白别名: 60S ribosomal protein L8 histidine hydroxylase; Bifunctional lysine-specific demethylase and histidyl-hydroxylase NO66; FLJ21802; Histone lysine demethylase NO66; hsNO66; lysine-specific demethylase NO66; myc associated protein with JmjC domain; Myc-associated protein with JmjC domain; Nucleolar protein 66; Ribosomal oxygenase 1; Ribosomal oxygenase NO66; ROX
基因别名: C14orf169; MAPJD; MNCb-7109; NO66; RIOX1
UniProt ID: (Mouse) Q9JJF3, (Rat) D3ZU57
Entrez Gene ID: (Mouse) 71952, (Rat) 314300